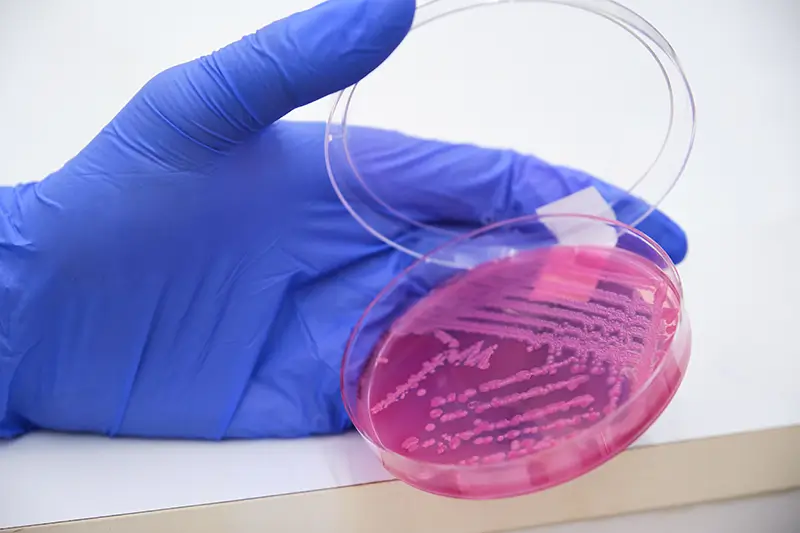

Methicillin-resistant Staphylococcus aureus (MRSA) is a type of staph bacteria that has become resistant to many common antibiotics such as methicillin, penicillin, oxacillin, and amoxicillin. Today, MRSA infections are present not only in hospitals but also many non-hospital settings. Medical billing companies help providers report MRSA correctly based on ICD-10 guidelines.
MRSA are commonly found on the skin and in the noses of healthy people. As it is hard to treat, MRSA is called a superbug. According to the Centers for Disease Control and Prevention (CDC), there were about 120,000 Staphylococcus aureus bloodstream infections and 20,000 related deaths in 2017 in the United States. MRSA causes skin infections and lung infections. Risk of infection is high in activities or places that involve crowding, skin-to-skin contact, and shared devices or supplies. MRSA infections usually occur in hospitals or other health care settings and are called healthcare-associated MRSA infections (HA-MRSA).
Risk Factors for HA-MRSA
- Hospitalization: In hospitals, MRSA can affect older adults and people with weakened immune systems.
- Invasive medical device: Intravenous lines or urinary catheters can cause MRSA to enter the body.
- Living in a long-term care facility: In nursing homes, carriers of MRSA may not be sick themselves but can spread the MRSA infection.
Symptoms of MRSA
The symptoms of MRSA depend on the area of the body that is affected. Typical signs include swelling, warmth, redness, and pain in the infected skin. On the other hand, MRSA can also cause serious skin infections or infect surgical wounds, the bloodstream, the lungs, or the urinary tract.
Some MRSA skin infections can look like a spider bite. The bump or infected area on the skin due to an MRSA infection may appear:
- Red
- Swollen
- Warm to the touch
- Filled with pus
- Painful and accompanied by a fever
Laboratory testing is usually necessary to confirm MRSA infections. Patients with weakened immune systems are at much greater risk of symptomatic secondary infection. It can happen that a person is a carrier of MRSA, but not sick with the infection. Those who have signs and symptoms of a MRSA infection are much more likely to spread MRSA because the infected area contains many MRSA germs.
Coding MRSA Conditions in ICD-10
There are four ICD-10 codes to report MRSA conditions: two main codes and two specific codes for a patient with MRSA sepsis or MRSA pneumonia.
- Main codes: The two main MRSA ICD-10 codes are A49.02 and B95.62. One of these two codes is usually listed first when a patient is treated for an MRSA infection.
A49.02 Methicillin resistant Staphylococcus aureus infection, unspecified site Code A49.02 is reported when infection site is not known
B95.62 Methicillin resistant Staphylococcus aureus infection as the cause of diseases classified elsewhere
The infection site is known and reported secondarily.
- Combination codes: When a patient is diagnosed with an infection that is due to MRSA, and that infection has a combination code that includes the causal organism (such as sepsis, pneumonia) the appropriate combination code for the condition should be assigned:A41.02 Sepsis due to Methicillin resistant Staphylococcus aureusJ15.212 Pneumonia due to Methicillin resistant Staphylococcus aureusA41.01 Sepsis due to Methicillin susceptible Staphylococcus aureus
J15.211 Pneumonia due to Methicillin susceptible Staphylococcus aureus
Note: Do not report a code from subcategory Z16.11, Resistance to penicillins, as an additional diagnosis for MRSA sepsis or pneumonia because the combination code captures both the infectious organism and the drug-resistant status.
- Other MRSA infections: If the physician documents an infection (such as a wound infection, stitch abscess or urinary tract infection) due to MRSA, which is not covered by the combination code, it should be reported using the code for the condition, followed by the code B95.62, Methicillin-resistant aureus (MRSA). This is done to indicate infection as the cause of diseases classified elsewhere and to identify the drug-resistant nature of the infection. In this case also, do not report Z16.11, Resistance to penicillins.
- MRSA or MSSA colonization: A person colonized with MRSA carries it in their nose or on skin but is not sick with a MRSA infection. Documentation of MRSA or MSSA colonization without documentation of a disease process due to the MRSA or MSSA is report using the following codes:Z22.322 Carrier or suspected carrier of MRSAZ22.321 Carrier or suspected carrier of MSSA
If the physician documents both MRSA or MSSA colonization and a current MRSA or MSSA infection, both the code for the MRSA or MSSA infection and the code for the carrier state should be reported.
- MRSA screening or testing: The CPT codes for reporting MRSA screening or testing are:87081 Culture, presumptive, pathogenic organisms, screening only87641 Infectious agent detection by nucleic acid (DNA or RNA); Staphylococcus aureus, methicillin resistant, amplified probe technique
A 2017 AAPC gives the instructions for the use of these CPT codes:
CPT code 87081 should be reported if a true screening is performed, as for hospital admission or when a skin or other accessible infection site is suspect. ICD 10 code Z22.322 should be reported to show the reason for the test, whether as a true screening or to screen for a symptomatic pathogen.
As healthcare providers focus efforts on reducing methicillin-resistant Staphylococcus aureus infections, an experienced medical coding company can help them report the condition accurately.